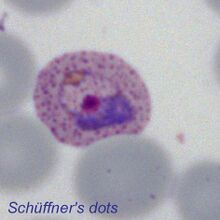

Added dots 2: Difference between revisions
From MalariaETC
No edit summary |
No edit summary |
||
| Line 8: | Line 8: | ||
|} | |} | ||
---- | |||
{| class="wikitable" style="widthe:90%; border-style: solid; border-width: 4px; border-color:teal" | |||
|colspan="1" style = "font-size:140%; color:black; background: FFFAFA"|<span style="color:black>'''Cytoplasmic dots'''</span> | |||
---- | ---- | ||
Latest revision as of 11:14, 22 March 2025
| Navigation |
| >Previous Page |
| Cytoplasmic dots
The dots found in the different species are parasite-derived proteins that modify the function of red cells in a range of ways that support parasite development, immune evasion or virulence. The precise functions of the dots in different pages are ill defined, but their appearances have value in distinguishing the different species of parasite. The dots require a well-stained specimen to be easily seen! Schüffner's dots (P.vivax) and James' dots) (P.ovale) become apparent during the early trophzoite as faint dots then to be easily seen in later stages. These two forms of dots are morphologically indistinguishable as frequent evenly-distrubuted round dots od similar size. Maurer's dots and clefts (P.falciparum) are blue/purple coloured and are not acquired until the late trophozoite stage of parasite development. They are less consistently "dot-like" and may appear as dots, clefts or plaques. Sinton and Mulligan's stippling (P.knowlesi) may appear similar. Ziemann's stippling (P.malariae) Is not usully seen, but when present appears as faint fine (and inconspicuous) dots in cytoplasm of some ifected erythrocytes. |